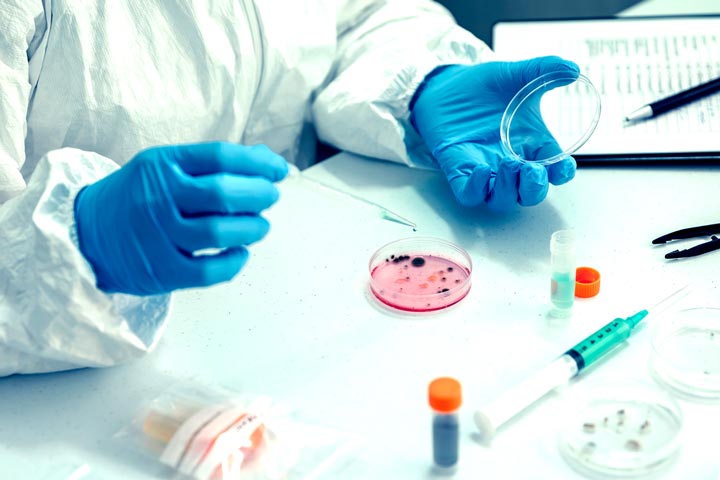
تخصص الجراثيم في ألمانيا

هل تفكر بالسفر إلى ألمانيا للتخصص والعمل وترغب بمعرفة معلومات عامة عن بعض التخصصات غير الحادة التي يمكن للطبيب أن يتابع التخصص والعمل فيها في ألمانيا؟
في هذه المقالة سوف تحصل على نظرة عامة على هذه التخصصات من وجهة نظر الطبيب، وسوف تطلع على طبيعة التخصص في هذه المجالات حسب نظام التخصص الألماني.

التخصصات المخبرية
الأشعة والتشخيص الشعاعي
العلوم الطبية الأساسية
التخصصات الدوائية
تخصصات أخرى
الخلاصة
تعتبر التخصصات المخبرية من المجالات المرغوبة نظراً لأنها تبتعد عن العمل السريري المباشر مع الحالات الحادة، مما يجعل ضغط العمل فيها أقل بشكل عام من التخصصات السريرية الحادة.
في ألمانيا يتم إدارة المخابر من قبل الفنيين المتخصصين في المختبرات، أما عدد الأطباء في كل قسم فيكون عادة قليلاً. ولذلك فإن الطلب على هذه التخصصات إجمالاً أقل بكثير منه على التخصصات السريرية الحادة، ولكن الحصول عليها هو أمر ممكن للأجانب.

يتطلب إجراء هذه التخصصات العمل في مجال المستشفيات، ومعظمها يحتاج إلى العمل لسنة واحدة على الأقل في المجالات السريرية مثل الطب الباطني.
وبعد الحصول على شهادة التخصص يمكن للطبيب الاستمرار بالعمل في المستشفى أو العمل في العيادات أو المخابر الخاصة خارج نطاق المستشفيات.
تتوفر في ألمانيا خمسة أنواع من التخصصات المخبرية التي يمكن للطبيب أن يحصل فيها على شهادة الفاخ أرتز: المختبرات، والجراثيم والأوبئة، ونقل الدم، والجينات البشرية، والباثولوجيا. سنتحدث في الفقرات التالية عن هذه التخصصات بشكل موجز.
طب المختبرات (Laboratoriumsmedizin)هو التخصص الذي يتضمن العمل مع التحاليل المخبرية بأنواعها والتعامل مع الأجهزة الخاصة بها.
مدة هذا التخصص في ألمانيا خمس سنوات، وهذه الفترة تشمل التدريب في عدة مجالات في الطب المخبري، على سبيل المثال يجب على الطبيب قضاء سنة على الأقل في المختبرات الجرثومية.
كذلك يطلب من الطبيب المخبري في ألمانيا إتمام سنة كاملة في أحد المجالات السريرية في المستشفيات، مثلاً الطب الباطني أو أي تخصص جراحي، وذلك للتعرف على التطبيق العملي للفحوص المخبرية عن كثب.

علم الجراثيم والفيروسات والأوبئة (Mikrobiologie, Virologie und Infektionsepidemiologie)هو التخصص الذي يتضمن العمل مع المزارع الجرثومية والتحسس للمضادات الحيوية والأحياء الدقيقة الأخرى مثل الفيروسات والفطور والطفيليات وكل ما يتعلق بالعوامل المُعدية والأوبئة.
هذا التخصص مدته أيضاً خمس سنوات. ويطلب كذلك من الطبيب أن يعمل لمدة سنة على الأقل في أحد المجالات السريرية في المستشفى. كما يمكن له قضاء سنة من فترة التخصص في المجالات المخبرية الأخرى.
طب نقل الدم (Transfusionsmedizin)هو أحد التخصصات الفريدة في ألمانيا. تبلغ مدة هذا التخصص خمس سنوات يمكن أن يقضي الطبيب منها ستة أشهر في أحد التخصصات المخبرية الأخرى.
في هذا التخصص يتلقى الطبيب تدريباً تخصصياً في مجال استعمال الدم ومنتجاته المختلفة وكل ما يتعلق بموضوع نقل الدم ومشاكله والأجسام المضادة والزمر الدموية الفرعية وما إلى ذلك.
وفي هذا المجال يجب على الطبيب أن يعمل على الأقل لمدة سنة ونصف في أحد التخصصات السريرية التي تتضمن التعامل مع مشتقات الدم، مثل الطب الباطني أو الجراحة.

علم الجينات البشرية (Humangenetik)هو أيضاً تخصص مخبري يؤهل الطبيب للعمل في مجال التحليل الجيني.
تستخدم التحاليل الجينية على نطاق واسع في ألمانيا، حيث تمتلك تطبيقات عديدة في كشف الطفرات الجينية والتشوهات لدى الأجنة وحديثي الولادة، بالإضافة إلى كشف الأمراض الوراثية والأورام العائلية عند وجود حالات متعددة في العائلات.
ومدة هذا التخصص تبلغ خمس سنوات يتوجب على الطبيب قضاؤها في مجالات مختلفة ضمن التخصص، نصف هذه الفترة يجب أن يكون ضمن عيادات الاستشارات الوراثية للمرضى.
في هذا الفيديو القصير من جامعة إينسبروك تحصلون على فكرة عن طبيعة العمل في هذا التخصص:
تخصص التشريح المرضي أو الباثولوجيا (Pathologie)هو من التخصصات الهامة جداً في ألمانيا، حيث تبلغ مدة التخصص الإجمالية ست سنوات، ويمكن إجراء سنة واحدة في مجال آخر.
يشمل العمل في هذا التخصص مجالين رئيسيين. المجال الأول هو دراسة العينات النسيجية والخلوية التي يرسلها الأطباء والجراحون، مثل الأورام المستأصلة أو الخزعات التي تؤخذ بالمناظير أو السوائل المسحوبة بالإبرة.
أما المجال الثاني فهو فتح الجثة (Obduktion)الذي يشمل تشريح جثث المرضى المتوفين لتشخيص سبب الوفاة، حيث يجرى ذلك في ألمانيا من قبل اختصاصيي الباثولوجيا. وفقط في الحالات الجنائية يجرى ذلك من قبل الطبيب الشرعي.

حين يحصل الطبيب على شهادة الفاخ أرتز في أحد التخصصات المخبرية الخمسة التي ذكرناها، فإن لديه الفرصة للعمل في أحد ثلاث مجالات في ألمانيا:
يعتبر تخصص الأشعة (Radiologie)من التخصصات الأنيقة والمرغوبة في ألمانيا. وهو يعتبر من التخصصات المريحة إجمالاً والتي لا تتطلب تماساً مباشراً مع المريض إلا في المجالات التداخلية.
وفي هذا التخصص يتعلم الطبيب كيفية إجراء وقراءة وتفسير الصور الشعاعية بأنواعها، سواءً تلك المجراة بالأشعة السينية، أو التصوير الطبقي المحوري والرنين المغناطيسي والأمواج فوق الصوتية والوسائل الشعاعية الأخرى.
في هذا الفيديو تجدون نظرة سريعة على ممارسة تخصص الأشعة في ألمانيا:
تعتبر الأشعة من التخصصات المرغوبة في ألمانيا وعليها بعض التنافس. ولذلك فإن الحصول على التخصص للأجانب قد لا يكون سهلاً. ويساعد إجراء سنة أو سنتين في تخصص سريري آخر بشكل كبير، كما أن اللغة الألمانية الجيدة تعتبر من المتطلبات الأساسية.
في معظم المستشفيات يكون دور الطبيب الشعاعي في مجال التصوير بالأمواج فوق الصوتية (الإيكو أو السونار) محدوداً نوعاً ما، وذلك لأن هذا الفحص يجرى عادة من الأطباء السريريين، كلٌ في مجال تخصصه، مثل أطباء الجراحة البولية أو الباطنية أو النسائية وحتى العظام والأطفال وأطباء التخدير في وحدات العناية المركزة.
بطبيعة الحال يتوجب على طبيب الأشعة إجراء مناوبات ليلية أيضاً، والتي تكون ضمن المستشفى في المراكز الكبيرة، أو من المنزل في المستشفيات الصغيرة، حيث يقوم الطبيب بالاطلاع على الصور الإسعافية ومساعدة السريريين في اتخاذ القرارات التشخيصية والعلاجية.
بعد إنهاء التخصص يمكن للطبيب الاستمرار بالعمل في مجال المستشفيات، كما يمكن له أن يعمل في مراكز التصوير الشعاعي الخاصة خارج نطاق المستشفيات.

ومن يرغب بإجراء تخصصات إضافية في هذا المجال فيمكنه ذلك في المستشفيات الكبيرة. ومن المجالات المتوفرة التخصص الدقيق في التصوير بالرنين المغناطيسي، وكذلك التخصص الإضافي في مجال الطب النووي (Nuklearmedizin)،والذي تحدثنا عنه بتفاصيل أكبر في مقالة تخصصات الأورام في ألمانيا.
ومن المجالات المتقدمة في ألمانيا نذكر مجال الأشعة التداخلية (interventionelle Radiologie)،والذي يتيح إجراء الكثير من التداخلات العلاجية بواسطة التداخل عبر الأوعية الدموية، مثل إيقاف النزف وقطع التروية الدموية عن الأورام وغير ذلك.
ولا تتوفر في ألمانيا مؤهلات خاصة للتخصص الدقيق في هذا المجال، ولكن يحصل الطبيب عند العمل فيه على الخبرة بشكل تدريجي إلى أن يصبح مؤهلاً للقيام بالتداخلات لوحده.
في ألمانيا يمكن للطبيب إن أراد متابعة التخصص في مجال العلوم الطبية الأساسية، ونعني بذلك على وجه الخصوص ثلاثة من العلوم الأساسية: التشريح (Anatomie)،والفيزيولوجيا (Physiologie)،والكيمياء الحيوية (Biochemie).
في هذه الحالة يعمل الطبيب كمقيم في أحد هذه الأقسام ويحصل على تدريب في هذه المجالات. وعند إنهاء التخصص يحصل على شهادة الفاخ أرتز، مثله مثل أي طبيب اختصاصي في المجالات السريرية الأخرى.
بطبيعة الحال فإن العمل في هذه المجالات يقتصر عادة على نطاق الجامعات، وبالذات التدريس والمختبرات. وعلى المدى البعيد قد تكون هناك أيضاً فرص عمل في شركات تطوير الأدوية أو المستحضرات الغذائية أو المعدات الطبية.
وهذه التخصصات الثلاثة مدتها أقصر من التخصصات السريرية، حيث تبلغ مدتها أربع سنوات فقط. ونظراً لقلة عدد المقاعد المتوفرة فإن الحصول عليها للأجانب قد لا يكون سهلاً.

من المجالات الفريدة التي يمكن أن يتابع فيها الأطباء في ألمانيا نذكر المجالات الدوائية والصيدلانية، حيث يمكن للطبيب أن يتخصص ويعمل في مجالات تقع بين الطب والصيدلة.
في الواقع هناك تخصصان في هذا المجال. التخصص الأول يدعى باسم علم الأدوية السريري (Klinische Pharmakologie)وهو يتضمن التطبيقات السريرية للمعالجة الدوائية ومشاكلها وتداخلاتها وغير ذلك من الأمور.
أما التخصص الثاني فيدعى علم الأدوية والسموم (Pharmakologie und Toxikologie)،وهو متخصص كما هو واضح في مجال السموم المختلفة وأعراضها وعلاجها.
تبلغ مدة هذه التخصصات خمس سنوات يحصل بعدها الطبيب أيضاً على شهادة الفاخ أرتز في مجاله. وفرص التخصص فيها أيضاً ليست متوفرة على نطاق واسع. أما مجالات العمل فهي تتراوح بين المستشفيات الكبرى والصيدليات حتى شركات الأدوية والأبحاث الدوائية.
نختتم هذه المقالة المنوعة بالتطرق إلى أربعة تخصصات لا تلقى عادة الكثير من الاهتمام من الأطباء الأجانب. مدة جميع هذه التخصصات تبلغ خمس سنوات، وفي نهاية التخصص يحصل الطبيب على شهادة الفاخ أرتز.
تشمل هذه التخصصات كلاً من الطب المهني، والطب الشرعي، والطب الوقائي، والشؤون الصحية العامة. وسنتحدث فيما يلي بشكل موجز عن هذه التخصصات.
الطب المهني أو طب العمل (Arbeitsmedizin)هو من التخصصات المهمة في ألمانيا وفيه فرص عمل جيدة للأطباء الأجانب أيضاً نظراً لوجود حاجة لهذا التخصص.
تعتبر كل شركة أو هيئة عمل في ألمانيا مجبرة على إجراء فحوص دورية للعاملين لديها والتأكد من إجراءات الوقاية واللقاحات وغير ذلك من الأمور، وبذلك فإن كل هيئة عمل لديها طبيب مهني يكون مسؤولاً عن ذلك.
وتعتبر طبيعة العمل في هذا التخصص مريحة إجمالاً، وذلك لأن فحص المرضى يتم من خلال مواعيد منسقة سابقاً ولا يوجد فيه إسعافات أو مناوبات، باستثناء سنتين يجب على الطبيب أن يقضيهما في المجالات السريرية في بداية فترة التخصص.

يحصل الطبيب خلال التخصص على معرفة نظرية واسعة في مجال الطب المهني. يتضمن ذلك الأخطار المترافقة مع المهن المختلفة وكيفية الكشف المبكر عنها والوقاية منها والنتائج التي يمكن أن تترتب عليها وغير ذلك من الأمور المرتبطة بذلك.
بعد إنهاء التخصص والحصول على الفاخ أرتز تتوفر فرص العمل في الشركات أو المستشفيات وكذلك في العيادات أو مراكز الطب المهني التي تتعاقد الشركات معها وترسل موظفيها إليها لإجراء الفحوص الدورية.
الطب الشرعي (Rechtsmedizin)هو التخصص الذي يتداخل مع القضاء وعمل الشرطة والمحامين، حيث يشمل إجراء الفحص الطبي في الحالات الجنائية والقضائية.
وتبلغ مدة هذا التخصص خمس سنوات يجب على الطبيب خلالها أن يعمل أيضاً لمدة ستة أشهر في مجال الباثولوجيا وستة أشهر أخرى في مجال الطب النفسي والمعالجة النفسية.
الطب الوقائي وطب البيئة (Hygiene und Umweltmedizin)هو أيضاً من التخصصات المهمة في ألمانيا، حيث يشمل موضوع الطب الوقائي الكثير من الجوانب المتعلقة بالصحة العامة.
ولكن المجال الآخر المهم لهذا التخصص هو التعامل مع الأمراض السارية وانتقال الأمراض والجوانب الوبائية لها. وكذلك التعامل مع الجراثيم المقاومة في المستشفيات والمراكز الصحية.
وخلال السنوات الخمسة من التخصص يتوجب على الطبيب العمل لمدة سنة على الأقل في أحد المجالات السريرية، بالإضافة إلى إمكانية إجراء جزء من مدة التخصص في مجالات الجراثيم أو الطب المهني.

الشؤون الصحية العامة (Öffentliches Gesundheitswesen)هو تخصص فريد يحصل فيه الطبيب على تدريب في مجال الصحة العامة وقرارات الإدارة الصحية، بما يؤهله في النهاية لأن يصبح طبيباً اختصاصياً ويعمل في وزارات الصحة.
وبذلك فإن هذا المجال متخصص بالعمل مع الدولة، حيث يقع بين الطب والإدارة الصحية والسياسة إذا صح التعبير. ولذلك فالدخول في هذا المجال محصور تقريباً بالأطباء الألمان، فالأجانب لا يهتمون بمثل هذه المجالات عادة.
وتتميز فترة التدريب التي تبلغ خمس سنوات بأنها متنوعة جداً، حيث يتوجب العمل لمدة سنتين في أحد المجالات السريرية، كما يجب العمل لفترة في مؤسسات الدولة وكذلك في أحد المجالات النفسية. وهناك كورسات خاصة يتوجب على الطبيب إتمامها.
في هذه الفيديو الذي تبلغ مدته دقيقتان تشرح طبيبة ألمانية طبيعة عملها في الشؤون الصحية العامة في مدينة برلين.
في هذه المقالة تحدثنا عن قائمة طويلة من التخصصات غير الحادة في ألمانيا، مثل التخصصات المخبرية والعلوم الأساسية والتشخيص الشعاعي وعدد من المجالات الأخرى.
تتفاوت إمكانية الحصول على هذه التخصصات، ولكن إجمالاً كلما كان التخصص أكثر راحة في ألمانيا كلما كان مرغوباً أكثر وبالتالي تكون التنافسية فيه أكثر.
إذا كانت لديكم المزيد من التساؤلات حول هذا الموضوع فيمكنكم طرحها على صفحات التواصل الاجتماعي. إذا كان لديكم أي تصحيح أو تحديث للمعلومات المذكورة في هذه المقالة فنرجو التواصل معنا مباشرة.
إن المادة العلمية والصور والميديا الموجودة في هذه المقالة محمية بشكل كامل بموجب قوانين الملكية الفكرية. يمنع نسخ أو نقل المعلومات إلى أي موقع آخر إلا من خلال الاقتباس العلمي المتعارف عليه. ومن خلال اتفاقيتنا مع شركة DMCA العالمية فسوف يتم إشعارنا بأي إعادة استخدام غير مشروعة للمواد الموجودة على هذا الموقع، الأمر الذي يمكن أن يعرضكم للمساءلة القانونية. للمزيد من المعلومات انظر صفحة حقوق النشر.